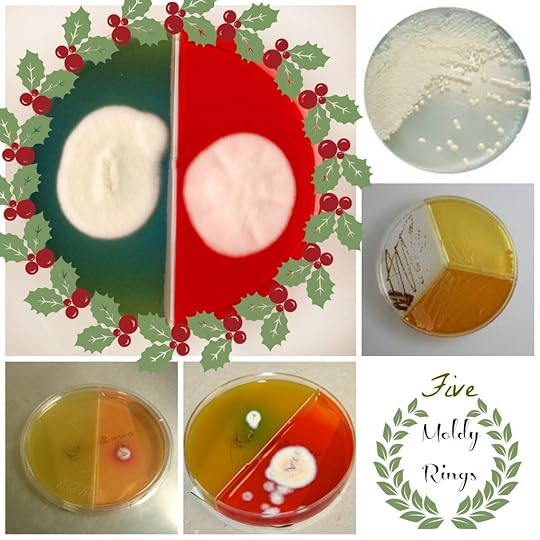
moldy rings

Jessica Vogelsang's Blog, page 13
December 17, 2014
On the fifth day of Clinics
On the fifth day of clinics, my ref lab sent to me:
4 Gastric grommets
3 Dead Pens
2 Blown up Gloves
And a linear Foreign Body!






December 16, 2014
On the fourth day of clinics
My clients gave to me:
3 Dead Pens
2 Blown Up Gloves
And a linear foreign body!
Thank you to Jessi J for the radiograph! She writes: “Boo ate a leather drawstring bag, and my only clue were a few remaining pieces of string. The radiograph was our confirmation…”






December 14, 2014
On the third day of Clinics…
On the third day of clinics, my best tech gave to me:
Two blown up gloves
And a linear foreign body!
Seriously, the agony of a stack of dead ballpoint pens when you just want to finish your records and go home still haunts me.






December 13, 2014
The Second Day of Clinics
December 12, 2014
The Twelve Days of Clinics
I miss singing the 12 days of Christmas with you all, so I’m working through the 12 days of Clinics from a clinic perspective. Feel free to toss me ideas- we have 12 days to work through after all.
Shall we begin?
On the first day of Christmas, my true love gave to me:
Tinsel never looked so sinister.






December 2, 2014
A Veterinarian’s Holiday Wish
It’s the holidays, and that means lots of things: peace on Earth, goodwill to men!

Was Brody this teeny on his first Christmas? Time sure flies.
Just kidding, it means cranky people fighting in the parking lot, someone getting shanked over the last PlayStation, and passive aggressive fruitcake gifts.
I wasn’t always this cynical. I, too, was once a merry-eyed elf with stars in my eyes and garland round my neck, until I worked long enough in veterinary medicine. Then I began to dread the month of December. It is a month of ill portents:
Too many people who blew their budget on Black Friday, cannot afford to work up their cat’s pancreatitis, and then blame it all on you in a waiting room explosion worthy of the Fourth of July;
The strange but consistent uptick in euthanasias the week before Christmas. Always.
Wondering where your card is from your favorite client then remembering with a pang of pain that they lost their dog to cancer in October. Yes, we feel sorrow for your pets. We love them too.
Hearing the two most dreaded utterances in veterinary medicine:
1. Fifteen minutes of telling us how every vet before us has wronged them, but we are awesome.
We’re not flattered. We’re terrified. We know it’s only a matter of time before we’re next on the naughty list.
2. The four words you must never say: “Money is no object.”
Translation: That’s because we have no intention of paying the bill. Been there, done that, many times.
So please forgive your vet if they seem a little more harried than usual, if their eyes are open a little wider than normal or their smile seems a little strained. It isn’t you. It’s December and they are bracing themselves is all. Should you wish to improve their month, aside from being the lovely clients I know you are (and appreciate more than you know!) I propose the following ways to make some vet’s day a little merrier:
Food, of course, always loved. Make sure to include the staff in the note. Usually they work as hard or harder than the vet and get none of the glory.
Did I mention food?
Cards. We read every one, especially on the bad days. I still have some from 2003!
Pictures of your pets. They make me smile and I love them.
And should you be stuck for ideas, I’ve made you some ecards:
Feel free to send one to your favorite vet. Trust me, it’s as good as cookies.






November 26, 2014
The greatest Thanksgiving ever
I grew up in New England, a place where tradition runs supreme. Holidays were a big deal, and we spent most of the major ones shuttling from this aunt to that grandmother and back again, enjoying the camaraderie only a large and extended family can afford. Those were the halcyon years, when my mother could still get away with dressing me as a doily.
When I was eight years old, we moved across the country to Southern California, and those days came to an abrupt end. We still celebrated every major holiday with all the pomp and circumstance my mother could bring to the table, but in the end it was always just us, and while it was still lovely, it was more….quiet, somehow. We called the family religiously, listening to the hubbub in the background and the people shouting in tipsy voices, “Tell em we said hi! What’s it, 70 degrees out thah? We’re jealous!” And so was I.
We always toyed with the idea of going back to spend the holidays with the family, just once, but the lure of nostalgia was overcome by my father’s distaste for holiday travel, so we remained home, year after year, in the quiet serenity of a sunny and warm Thanksgiving and Christmas.
In 2003, I was just celebrating my first anniversary, settling into a new job, when my mother told me her father, my beloved Pepe, was in trouble. He had been in trouble his whole life, truth be told, but it was a different kind of trouble this time.
In all the old pictures from my childhood, you could see Pepe smiling with the ineffable twinkle of a person who liked to tell stories, usually embellished. Always embellished.
The other thing you could always find, when you looked hard enough, was the small rectangular outline of a box of cigarettes.
We tried for years to get him to quit, bought cartons and emptied them out only to replace the contents with candy, but to no avail. He did quit eventually, when he was finally diagnosed with lung cancer about 20 years after it should have happened, but of course by then it was too late.
We visited him at the start of his radiation therapy, and my mother, who had long missed the embrace of her family more than the rest of us put together, spent a lot of time with him helping him get set up.
She’s a nurse. Of course she would be his caretaker. And when he rallied, he sent her back home to California.
Several months later, she was once again beckoned to New England. Pepe was doing poorly, and now he was in the care of hospice. Did she want to come, they asked. And she did.
She warned us that this time it was different, that the end was actually coming. If we wanted to say goodbye, she told us, we should be ready.
The week before Thanksgiving, Mom called both my sister and I and told us that Pepe had only days left, and should we wish to say our goodbyes, we should get on a plane. So we did.
The story of his passing is for a different time, but suffice it to say he did it his way, like he always did, and as strange as it is to say, we spent a good deal of those last hours laughing even through our tears.
He died on November 23, 2003. He was to be buried the following week, and Thanksgiving was only 4 days away. We piled into my aunt’s home, collapsed in the basements and crammed into the living room, while my aunt tried to manage both the grief of her father’s death and the sudden influx of new guests. The preparation was a welcome distraction. She shopped for turkey while my mother took my grandmother coffin shopping. “Mom picked our her own while we were there,” she said with some chagrin. “She always was a bit of a control freak.”
I don’t remember what we ate, balanced on paper plates on our laps. I don’t remember the pie or the turkey though I know we had them all. I remember laughing my butt off at regular intervals, my father looking in horror at the assembled group and asking, “Why are you all smiling and laughing? Your grandfather just died.”
And my mother smiled back and said, “Because he would have been so happy to see us all together again. This is what he would have wanted.”
Even if it took him dying to do it. Stubborn man.
Life gives us beauty when we least expect it, and what I am most thankful for is the ability to recognize those moments when they arrive. A blessed Thanksgiving to you all, my friends, and may you find your beauty in strange places as well.






November 20, 2014
The Long Dark Twee-Time of the Soul
As you probably know, I have a bit of a complicated relationship with the PTA moms. Not moms in general, mind you, just the small subset of Pinterest loving, glue-gun wielding domestic lifestyle experts whose expectations I can never, despite my best efforts, seem to live up to. It doesn’t matter what school we’re at, it happens every time. First it was the art project/pooper scooper incident in kindergarten. Then it was the Have a Very Agro Valentine’s Day episode. And now it’s crudite, crudite that torments the soul.
It started simply enough: an email asking for volunteers to bring in food items for the teachers this conference week. I looked on the sign up sheet and put my name next to crudite: veggies and dip. Easy, I thought, a quick run to the grocery store for some carrot sticks and dip and done.
I forgot where I was.
(Not two weeks ago, I found myself in the midst of a malestrom for the fifth grade Halloween party when all the room moms got together and asked the parents to bring in food. I asked my class parents to bring in pretzels and fruit. The other moms showed up with cookies shaped like rotting fingers with almond nails and jelly blood, and eyeball eggs with veins hand-painted on with food dye. My pretzels were shoved under the table.)
So now, a few minutes after signing up for the veggie tray, I received an email instructing me to be creative! which is always concerning. To illustrate her point, the organizer included this helpful photo:
As to what our vegetables should aspire to be.
Now at this point a normal person would laugh and say, “OK, lady,” and bring in a tray from Costco, but unfortunately I still have the sin of pride to contend with on a regular basis, so I instead spent the afternoon standing in line at the grocery store watching YouTube videos of Martha Stewart blanching asparagus. Three hours of cursing later, with piles of peeled burnt chestnuts and carrot shavings dripping out of my hair like Jackson Pollock on a bender, I came up with this:
This is the dogged tenacity that makes people like me get through vet school even when all indicators point to the “why?” factor. We can’t explain it. We just have to.
I shared this with my friends, and they all got a good laugh out of how silly it was, and then later in the day my friend in Ohio sent me a link and said, “See? You’re not alone.” It was a photo of some artfully arranged food items a group of mothers had arranged for their teachers.
It was, upon further inspection, a photo from my very school from earlier in the day. It had already made the Pinterest rounds and ended up in Ohio, where my friend saw it and sent it to me as an example of Moms Gone Styled. I scrolled through it, looking for my contribution.
Notably lacking? The crudite. They were apparently so lackluster as to have not even rated a Facebook photo, and when I returned to pick up the dish I found they had been shoved in the corner in order to make way for some gluten free turkey wraps with hand-whisked dressings in, of course, Mason jars.
At this point, even a not quite normal person would just give up, which is theoretically what I should do, but it’s become clear to me I live in a parallel universe where I am destined to almost-quite get it, over and over and over, but not get it entirely. This is why I am a veterinarian, the almost-quites of the medical field.
So you know what? I’m embracing it. This afternoon I decided to go on a Pinterest binge and make a little Pinterest and dog-friendly crudite platter my way. Hope you enjoy it.
A bright autumn day, full of promise and gently whispered secrets amongst best of friends, calls for sustenance.
Lovingly hand-extruded kibble, with ingredients sourced from local artisans in an organic human-grade facility in Portland by men with bushy beards. In a Mason jar.
We end our afternoon in the garden of delights (it’s water friendly succulents! We’re eco friendly here in drought-parched SoCal) with hand-cut carrot bones from the local CSA, mint from the garden, words of wisdom from the dog sketched in canine-friendly peanut butter hand ground at Whole Foods. And of course, no pet garden of delights would be complete without the coup de grace:
nitrate free ham roses.
You saw it first here, folks. I’m waiting on sponsors for a YouTube tutorial but I think a ham bouquet is a lovely thing.






November 10, 2014
Rumble in the Doghouse: Evil Breeders vs Crazy Animal Rights People
There was a time, back in a pre-internet era known as the Good Old Days, when two people who had different opinions on a topic could talk about it and, even if they did not come to an understanding, could at least part ways with a better grasp of the other person’s point of view. People with different opinions were still, at the end of the day, people.
I’m not entirely sure that is the case anymore.
Lest anyone doubt me, proof enough should be the fact that we’ve just come off an election cycle. I live in an area with one of the most hotly contested Congressional races in the country, better known to us locals subjected to the campaign ads as “Mouthbreathing Carbuncle-Having Satan Worshipping Slimeball” versus “Luciferous Mucusbucket Festering Wound.” (Definitions supplied by opposing parties.)
It was a close race. I think most of us voted for one or the other not based on deep unabiding adoration so much as we held our noses and selected the one we found less odiferous. Nonetheless, after the Slimeball defeated the Festering Wound by the narrowest of margins, the loser went on the air and graciously wished his opponent “all the best”, which is a strange thing to wish someone you truly thought was the Antichrist. If you truly thought he was the path to death and destruction, you think one would continue to rage against the injustice of it all and exhort people to do something to undo this miscarriage of justice.
But politicians know the truth that a lot us seem to have forgotten. All that bluster is just that, bluster. And at the end of the day they actually have a lot more in common than not:
both middle aged men of the same demographic savvy enough to be successful in local politics
Neither advocates overthrowing Congress and disbanding the Constitution
both against selling tanks to minors
Both for free sunlight
Both generally want to work for the constituents in order for people to live well in our beautiful city, though their ideas of how to get there might vary.
And now they will retreat to their corners to do whatever it is they do until they are again required by the tenor of American culture to again start yelling about how much the other person stinks.
Rumble In the Doghouse
We all know this about politics, we all roll our eyes with the silliness of it all, but don’t be mistaken- this “live and die by the sword”, “you’re with us or you’re worthy of a messy death” attitude has permeated many corners of our lives, and it’s not pretty.
The first time I met someone at a breeder’s event, I started talking to a person very involved with the dog fancy world. When she learned what I did, she looked at me a little sideways and said, “So you’re an animal rights person.”

PETA, protesting that abhorrent group of animal haters known as the American Veterinary Medical Association (true story).
“Not animal rights. Animal welfare,” I corrected her, as the person who introduced us (you know who you are, you rotten troublemaker) rubbed his palms together and waited in glee for us to start ripping each others’ hair out.
“What’s the difference?” she asked. So I called her a puppy mill, because all breeders are the same, right?
We looked at each other, hesitated a moment, then burst into laughter as she said, “Point taken.” We’ve been friends ever since.
I suppose in another world, maybe hidden behind an anonymous screen and keyboard, we could have become mortal enemies, but we’d spent too much time face to face to be able to call the other person demon spawn. We both knew we had too much in common, including:
a love of good wine
writing long and probably way too involved stories
thinking dogs are the absolute bee’s knees. We both totally adore and spend most of our free time thinking about, canines.
This friend recently began a Kickstarter campaign to create a website commemorating National Purebred Dog Day. Now, I’m not trying to convince anyone to go and support the campaign if it’s not your thing, no more than I would try and convince someone to donate to a political candidate they did not agree with. But the simple fact that she waited a long time to even begin the campaign because she was nervous about people targeting her for being an Evil Dog Person is honestly, pretty sad. I feel the same way about that as I do people who target pittie advocates trying to end BSL: why would you do that? We are not each other’s enemies here.
Who’s right?
A few weeks ago I wrote a piece for Vetstreet about purebreds versus mutts. I wonder if perhaps the editor was wanting me to go for the easy kill, the one that would bring 5000 shares and bloodshed in the comments section: quote people talking about how wrong the other side was, how misguided. But I didn’t want to do that.
We want people to find the right dog for their family so they keep them forever.
They had different ideas about the best way to do that, but they’re both perfectly valid approaches, really, and people have been using both successfully for some time. Let me repeat: at the end of the day we all want the same thing. The rest is just window dressing.

Can you tell which dog is more worthy, loved, or better for my family? I can’t.
Who’s the real enemy here? Apathy. Ignorance. Greed. Say what you want about either the dog fancy or the rescue community (and indeed, the large numbers who belong to both): they are not apathetic people. They care, and they want what’s best. Instead of shaking your fingers at the other side’s perceived shortcomings, listen. There is much to be learned, on both sides. I know this from experience.
It’s very easy to continue to point and shoot at the easy target. Keep on doing it if it makes you happy. It certainly makes life easier for the people at CheapPuppyMillDog.com; whenever someone gets turned off by the antics they encounter at either end of the spectrum, guess who’s waiting with open arms?
We are not each other’s enemy. If you want someone to hate on who really deserves it, I suggest these idiots. Seriously, no redeeming qualities whatsoever.






October 28, 2014
Halloween has hit rock bottom
Things were simpler back in the 80s. We only has three things to do the week before Halloween:
1. Watch the Great Pumpkin.
2. Carve a pumpkin. No one helped. If you cut your finger off, oh well.
3. Run to Woolworth’s and pick out your plastic costume that tied in the back like a surgeon’s gown and suffocating mask you could only see out of one eyeball at a time. Trying not to kill yourself tripping over the pavement was half the fun.
And that was it. Our biggest worry at the time was the ever ubiquitous ‘old man hiding razor blades in apples’ trick, which we were all scared of but no one actually ever saw.
I long for those simpler times. My week has been, shall we say, a bit more complicated.
1. Who has time to watch the Great Pumpkin? I have a Halloween party to plan at school. Except we can’t call it Halloween, so it’s a “Harvest Party” (with costumes) in grade 3 and a “Mystical Science Party” (with costumes) in grade 5. Two weeks ago I was summoned to a summit of all the room moms so we could coordinate our party activities, which were delegated as follows:
candy potions lab
luminescent fingerprint experiment
homemade spooky finger cookies
dry ice punch
Pretend blood coagulation experiment
I missed the meeting. When I was asked after the fact what I’d like to do I offered to contribute some sort of preserved creature in formaldehyde, which was the best I could do. I was assigned plates and cups.
2. Pumpkin carving has now become an Olympic sport.

No!

No!

Nooooo!!!
My garage is filled with half-used Pumpkin Masters and the sad remnants of plans gone awry. This year, we’re painting them and calling it a day.
3. Costume shopping began two months ago when the Chasing Fireflies catalog arrived. They cost a small fortune, but they are the only catalog where ten year old girls are still allowed to be ten year old girls.

Over my dead body.
“Why aren’t you wearing a costume, Mommy?” asked my daughter.
“Because I can’t find anything I like, honey,” I responded.
“How about a dog?” she asked. “You like dogs.”

That was out.
“Maybe I’ll just be a veterinarian,” I said. “That’s hard to mess up.”

DANGIT!!
Desperate, I tried to think of the least sexy things on the planet. A lamp. A body bag. A hazmat suit.

We’re all doomed.
“I don’t think that’s going to happen,” I said to her. “Maybe we can just get Brody a costume instead.”
Or maybe not.
Go home, Halloween. You’re drunk.